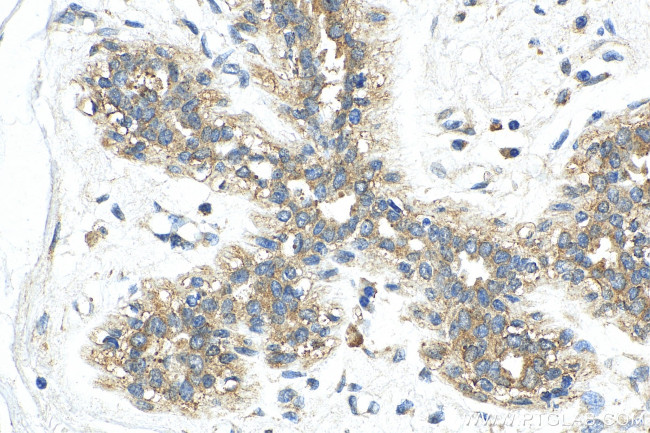
USP37 Antibody in Immunohistochemistry (Paraffin) (IHC (P))

Search
Proteintech
USP37 Polyclonal Antibody
{{$productOrderCtrl.translations['antibody.pdp.commerceCard.promotion.promotions']}}
{{$productOrderCtrl.translations['antibody.pdp.commerceCard.promotion.viewpromo']}}
{{$productOrderCtrl.translations['antibody.pdp.commerceCard.promotion.promocode']}}: {{promo.promoCode}} {{promo.promoTitle}} {{promo.promoDescription}}. {{$productOrderCtrl.translations['antibody.pdp.commerceCard.promotion.learnmore']}}
产品信息
18465-1-AP
种属反应
已发表种属
宿主/亚型
分类
类型
抗原
偶联物
形式
浓度
规格
纯化类型
保存液
内含物
保存条件
运输条件
产品详细信息
Immunogen sequence: MLTLQDNSF LSIDKVPSKD AEEMRLFLDA VHQNRLPAAM KPSQGSGSFG AILGSRTSQK ETSRQLSYSD NQASAKRGSL ETKDDIPFRK VLGNPGRGSI KTVAGSGIAR TIPSLTSTST PLRSGLLENR TEKRKRMIST GSELNEDYPK ENDSSSNNKA MTDPSRKYLT SSREKQLSLK QSEENRTSGL LPLQSSSFYG SRAGSKEHSS GGTNLDRTNV SSQTPSAKRS LGFLPQPVPL SVKKLRCNQD YTGWNKPRVP LSSHQQQQLQ GFSNLGNTCY MNAILQSLFS LQSFANDLLK QGIPWKKIPL NALIRRFAHL LVKKDICNSE TKKDLLKKVK NAISATAERF SG (1-351 aa encoded by BC112901)
靶标信息
Deubiquitinase that antagonizes the anaphase-promoting complex (APC/C) during G1/S transition by mediating deubiquitination of cyclin-A (CCNA1 and CCNA2), thereby promoting S phase entry. Specifically mediates deubiquitination of 'Lys-11'-linked polyubiquitin chains, a specific ubiquitin-linkage type mediated by the APC/C complex. Also mediates deubiquitination of 'Lys-48'-linked polyubiquitin chains in vitro. Phosphorylation at Ser-628 during G1/S phase maximizes the deubiquitinase activity, leading to prevent degradation of cyclin-A (CCNA1 and CCNA2) (PubMed:21596315). Plays an important role in the regulation of DNA replication by stabilizing the licensing factor CDT1 (PubMed:27296872). [UniProt]
仅用于科研。不用于诊断过程。未经明确授权不得转售。
生物信息学
蛋白别名: Deubiquitinating enzyme 37; tmp_locus_50; Ubiquitin carboxyl-terminal hydrolase 37; ubiquitin specific peptidase 37; ubiquitin specific peptidase 37-like; ubiquitin specific protease 37; Ubiquitin thioesterase 37; ubiquitin thiolesterase 37; Ubiquitin-specific-processing protease 37; usp37
基因别名: 4932415L06Rik; C330008N13Rik; KIAA1594; USP37
UniProt ID: (Human) Q86T82, (Mouse) Q8C0R0
Entrez Gene ID: (Human) 57695, (Mouse) 319651, (Rat) 100361658